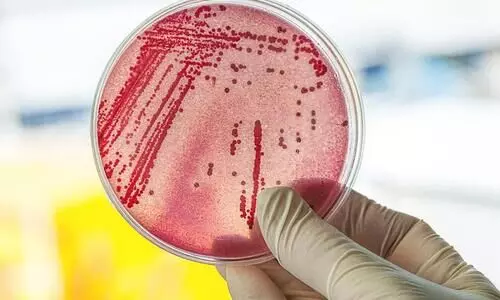
Coliform bacteria

Begin typing your search above and press return to search.
Coliform bacteria
access_time 23 Oct 2025 1:38 PM IST
access_time 21 Oct 2025 4:08 PM IST
access_time 5 April 2025 9:43 AM IST
access_time 29 Jun 2024 10:15 AM IST
access_time 23 March 2023 12:33 PM IST
access_time 10 Jan 2023 9:30 AM IST
access_time 16 May 2022 7:23 AM IST
access_time 27 Dec 2021 9:56 AM IST